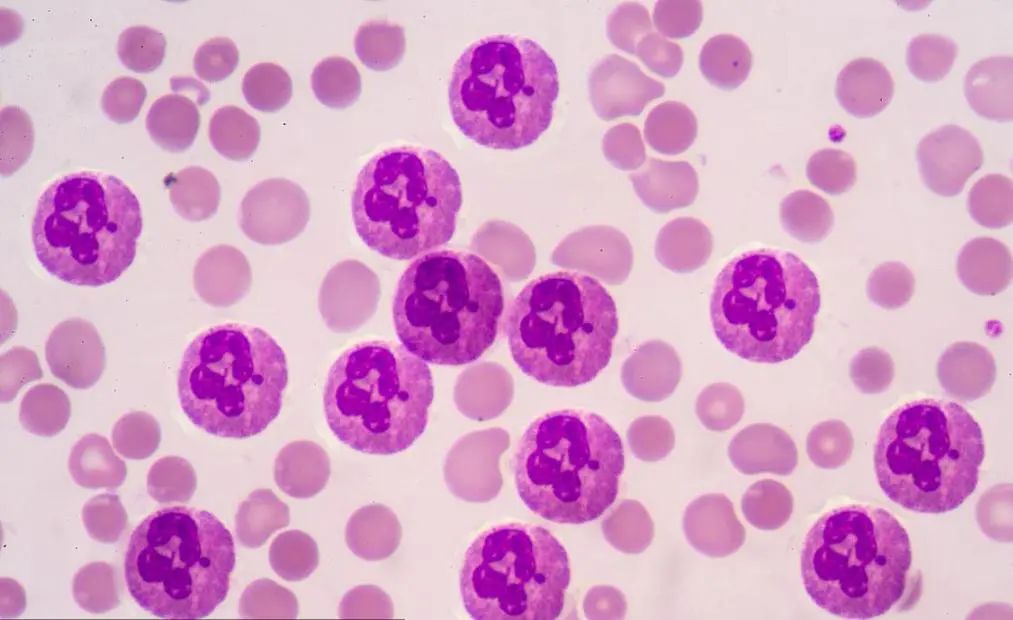
警惕！东莞女子确诊甲亢后服药治疗，一场小“感冒”却险些丧命！医生提醒······

前段时间,东莞39岁的程姐被确诊为“甲亢”,经过药物治疗后,病情有所好转。
但就在这时,一场看似“普通”的喉咙痛和发烧,却让她一度性命垂危。
好在当时东城医院内分泌科团队及时发现,积极抢救,程姐最终才顺利死里逃生。
这究竟是怎么回事呢?下面程姐这段“险象环生”的经历,希望能引起各位,甲亢服药患者及家属的警惕!
危险!甲亢服药险些“致命”
今年5月,程姐在一次常规体检中查出“甲亢”,医生很快为她开出了治疗甲亢的常规药物——甲巯咪唑。由于用药对症,程姐的病情很快出现了好转。

到了6月底“龙舟季”,东莞的雨水频繁,气温变化大,程姐身边有很多同事和朋友都陆续“中招”了,感冒流鼻涕的人不少。
就在这时,程姐也开始出现喉咙肿痛、高热不止的症状。“估计是重感冒吧,吃点感冒药,过两天估计就好了。”程姐心里想。
6月28日,咽痛加剧、高烧40℃的程姐来到东城医院风湿免疫内分泌肾病科就诊,此时她服用甲亢药物已有一个多月。
甲亢、咽痛、发烧······风湿免疫内分泌肾病科副主任李仿模接诊后,立马警惕起来:这会不会是正在服用的甲亢药物引起的血液系统损伤?于是立刻为程姐进行了血常规检查。
而检查结果瞬间让大家瞬间捏了一把冷汗:程姐的白细胞数值低至0.99x10^9/L,远低于正常值(4.0-10.0)x10^9/L,中性粒细胞绝对值低至0.01x10^9/L,远低于正常值(2.0-7.0)x10^9/L。
这也意味着,程姐的免疫系统崩溃了,情况非常危急!

6月28日 程姐的血常规报告单
原来,程姐遇到的不是单纯的“感冒发烧”,而是可能会危及生命的粒细胞缺少症!一旦发生感染,性命将岌岌可危。
中性粒细胞减少症
中性粒细胞占人类所有白细胞的40%至70%,在免疫系统中起着十分重要的作用,可以吸收纳米颗粒和吞噬死亡的红细胞,并在激活后清除外来病原体和加载靶点。当人体出现感染或炎症时,中性粒细胞就会帮助机体抵御感染等疾病的发生。
中性粒细胞减少症是指由多种病因和不同发病机制所致中性粒细胞减少或缺乏,严重者易合并各类感染,疾病异质性强,是常见的临床问题。中度和重度减少者易出现咽痛、乏力、头晕、食欲减退等非特异性症状。粒细胞缺乏者的感染风险极大,常见的感染部位是呼吸道、消化道及泌尿生殖道,重者可出现高热、感染性休克,甚至会危及生命,导致死亡。
好在病情发现及时,随后程姐立即进入东城医院风湿免疫内分泌肾病科住院治疗。
考虑到病情危急,为了让程姐安全度过粒细胞缺乏危重期,科主任马超带领团队制定了全方面的治疗方案,为免疫力极其低下的程姐安排单独病房隔离治疗,并采取重组人粒细胞刺激因子升高白细胞、抗感染、减慢心室率等治疗方法稳定病情。

6月30日8:29,检验科突然发来危机值报告,程姐的中性粒细胞绝对值跌至0!
风湿免疫内分泌肾病科团队立即进入抢救状态,进行丙球及大剂量激素冲击,加强抗感染、提升免疫力、监测血常规等对症治疗。
时间一分一秒地过去,病房内来回穿梭的医生和护士紧张而有序地忙碌着。最终,在大家的严密观察和尽心救治下,病情反复的程姐顺利度过危险期,转危为安。
经过9天的住院治疗,程姐的中性粒细胞终于由当时极低的0.00x10^9/L上升至正常范围内的5.09x10^9/L,各项指标明显好转。
“真的非常感谢!如果不是你们的及时发现和尽心抢救,后果难以想象!”出院时,程姐连连感谢医护人员。

程姐的血常规各项指标明显好转
马超主任特别提醒:“甲亢患者在用药期间,需要警惕由药物造成的粒细胞缺乏。大多数的粒细胞缺乏症病例都出现在服药最初的90天,建议患者在这期间每周都进行血常规监测。并且,药物治疗期间如果出现了咽痛或者发烧的症状,必须立即停药并及时到医院就诊。”
